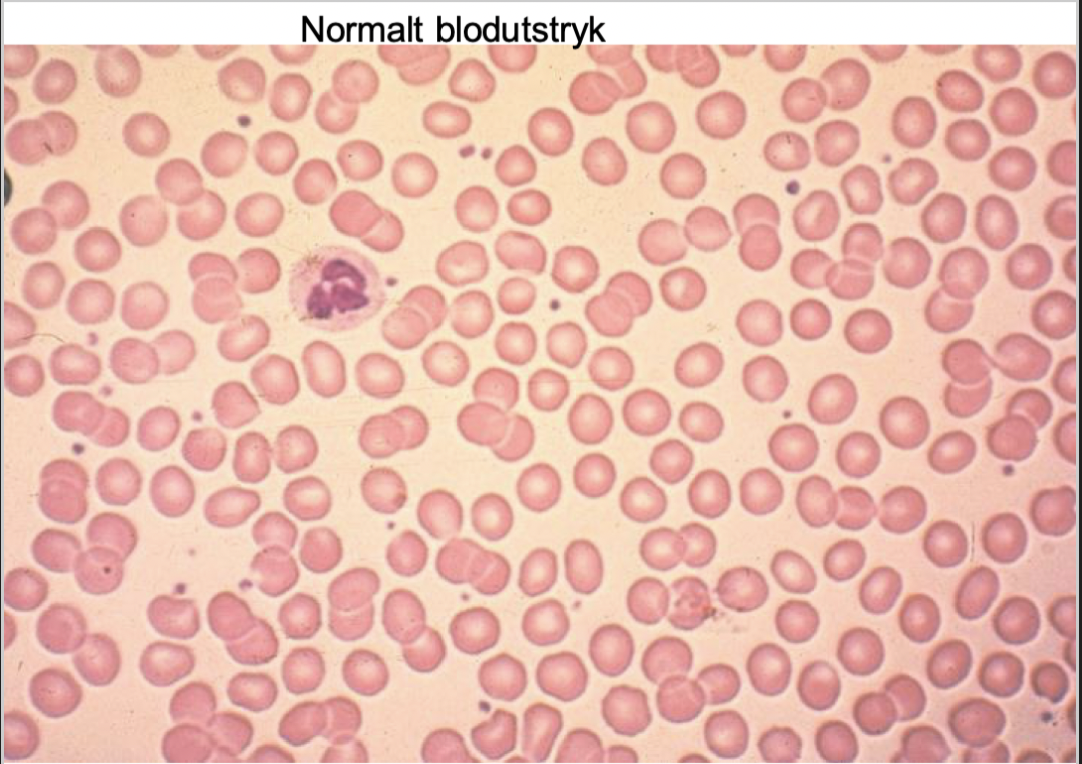
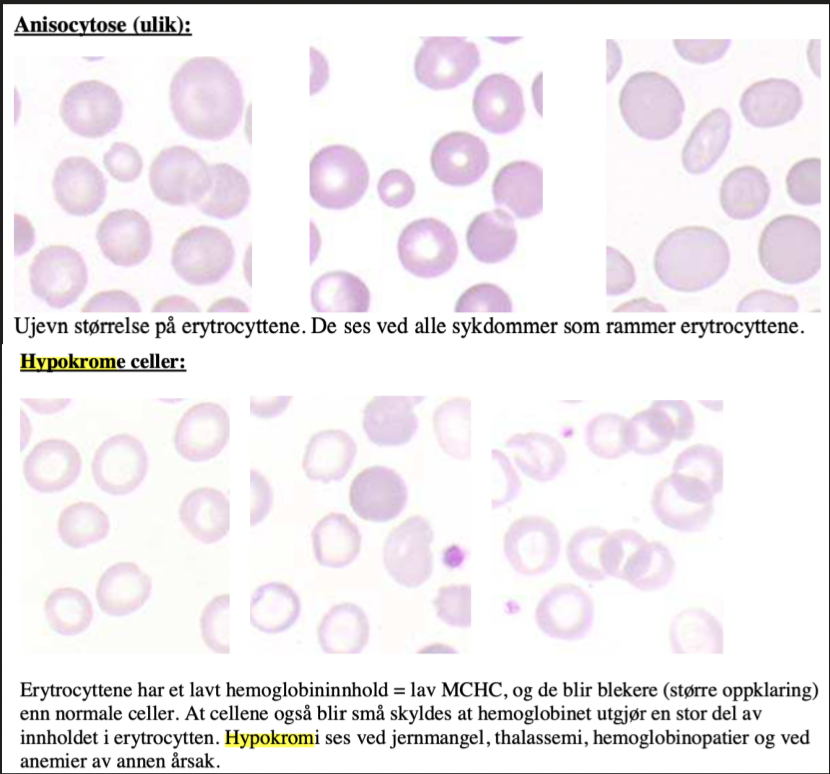
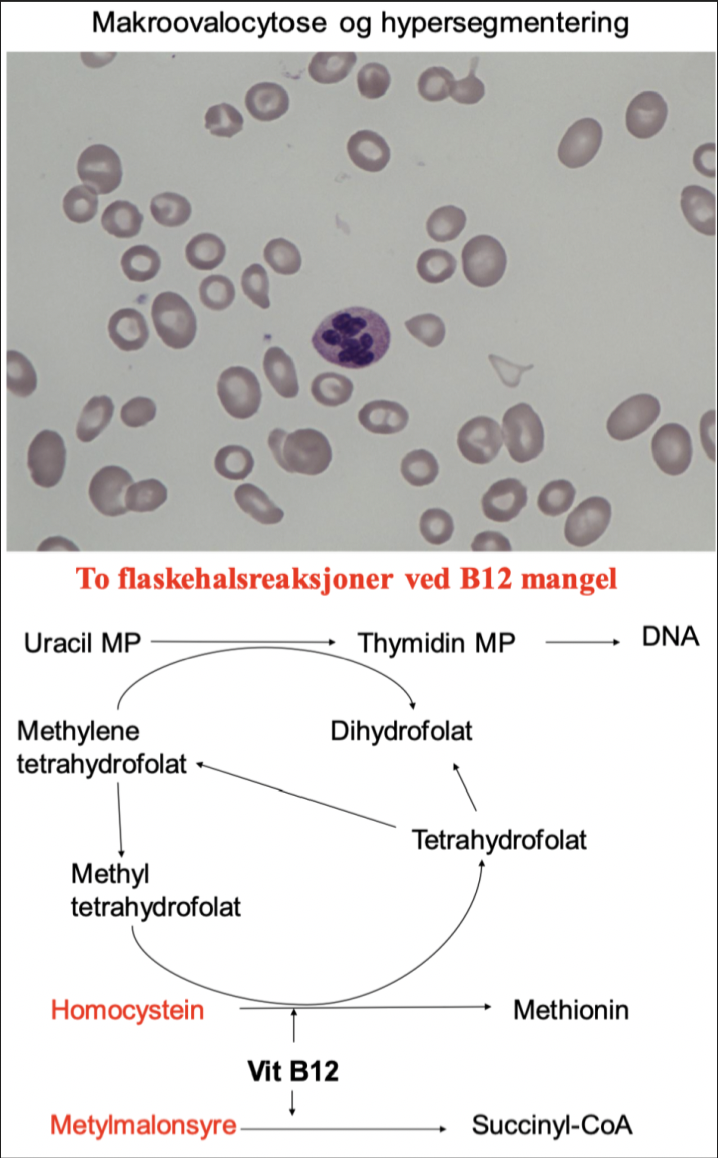
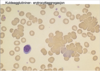
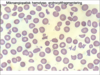

Hva slags medisinsk betydningen har anemi?
Global prevalens:
- Minst 1/4 av jordens befolkning er anemiske
Anemi forårsaker masse nedsatt helse og Quality of life (QoL)
Stort u-landsproblem:
- Jernmangel
Kvinner er mer anemiske enn menn
Hemoglobinopatier er vanlig og knyttet til malariasykdommen
Hva er viktig når de kommer til anemi?
Anemi er ingen diagnose!
Anemi er redusert B-Hb konsentrasjon; konsekvens er redusert oksygentransport
Årsaken må identifiseres
Hva er normalområdene for Hb for kvinner og menn?
Kvinner: Hb 11.5-15.5
Menn: Hb 13.5-17
Husk:
- Mulig å falle fra 17 til 13.5 innenfor normalområdet; derfor viktig å sjekke habituelt nivå
Fall på 2 g/dL er patologisk
Hva vil skje med Hb-verdien ved akutt blødning?
Akutt blødning endrer erytrocyttmengden, men ikke Hb-konsentrasjonen initialt

Hva vil endringer i plasmavolum gjøre med Hb-konsentrasjonen?
Endring i plasmavolum endrer Hb-konsentrasjon, men ikke alltid erytrocyttmengden

Hvilke kompensasjosmekanismer har man ved anemi?
Økt hjertefrekvens
Økt slagvolum
Omfordeling av blodvolum:
- CNS, hjerte, lunger har høy prioritet
- Tarm, hud (blekhet), ekstremiteter har lav prioritet
Økt perifer O2 ekstraksjon
Økt 2,3-DPG (diphosphoglyceric acid) i erytrocytter
Hva er symptomer og tegn på akutt blødning, f.eks. ulcusblødning?
Hypovolemi:
- Takykardi
- Blek
- Perifert kald
- Cerebralt omtåket
- Høy puls
- Svimmel
Ortostatisk bloddtrykksfall > 25 mmHg
OBS!:
- Normal eller lett nedsatt Hb initialt
Hva er alvorlige symptomer og tegn ved anemi?
Dyspné i hvile:
- Hjertesvikt
Cerebral påvirkning:
- Synsforstyrrelse
Synkope i stående stilling:
- Utelukk hypovolemi
Transfusjon aktuelt v/disse symptomene:
- Mortalitet begynner ved Hb på 5 g/dL
Hvilke anemi-mekanismer finner man?
Redusert produksjon:
- Mangel på byggematerialer; Fe, B12, folat
- Bortfall av stimulerende hormon; EPO, thyroksin, kortisol, androgen
- Hemmende cytokiner ved inflammasjon
- Defekt fabrikk; benmargssykdommer; f.eks. aplastisk anemi og krefttilstander
Økt tap:
- Blødning
- Hemolyse
Genetiske betingelser:
- Talassemi
- Sigdcelleanemi

Hvordan inndeler man anemi etter erytrocyttstørrelse og hemoglobininnhold (MCV/MCH)?

Hvordan går man frem med anamnesen ved anemi?
Hvilke us. er aktuelle?
Spør om sykdommer som kan forklare anemien:
- Kronisk inflammatorisk sykdomstilstand?- Autoimmunt, infeksjoner inkl. abcess
- Kreft?
- Nyresvikt?
- Endokrin svikt?
- Hjerteklaffprotese?
- Anoreksi?
Undersøkelse:
- Eksplorasjon med Hemofec
- Glossitt; glatt tunge?
- Abdominalus.; tumores og ømhet
- Skopier
Hvordan vurderer man produksjonen av erytrocytter?
Retikulocyttall:
- 0.7-2% (0.03-0.11 x 10^12/L)
- Se på andre cellerekker (hvite og trc)
Benmarg:
- Erytrpoiese > 20% med full differensiering
Hva ser man på ved blodutstryk?
Ser på:
- Mikrocytose, hypokromasi
- Makrocytose
- Sfærocytter (små, hyperkrome)
- Kjerneholdige RBC, retikulocytter
- RBC aggregasjon
- Fragmenterte RBC
- Inklusjoner; malaria
Når er det indikasjon for benmargsundersøkelse?
Ved mistanke om beinmargssykdom:
- Aplastisk anemi
- Leukemi
- Myelodysplasi
- Lymfom
- Myelomatose
Ved leukopeni eller trombocytopeni sammen med anemien
Unødvendig ved:
- Blødning
- Påvist mangel; Fe, B12, folat
- Hemolyse
- Inflammasjonsanemi
- Nyresvikt
Hvordan kan man vurdere mangel på jern?
S-ferritin < 20 = jernmangel:
- Ved samtidig inflammasjon kan jernmangel foreligge opp mot 50
Transferrinmetning (s-Fe/TIBCx100) < 10%
- Kan bekrefte diagnosen, men oftest unødvendig
Løselig transferrinreseptor økt

Hvordan kan man se mangel på jern ved blodutstryk?
Bevis på tomme lagre:
- Ikke fargbart jern i benmargsfragmenter
Funksjonell jernmangel gir små, hemoglobinfattige RBC:
- Mikrocytose (lav MCV)
- Hypokromasi (lav MCHC)
MCV < 74 skyldes alltid jernmangel hos pasienter med norsk etnisk bakgrunn
Ved lav MCV kan utredningen med en gang fokuseres på å finne årsaken til blodtap/jernmangel
Hva kan årsaken til jernmangelanemi være?
Skyldes vanligvis kronisk blodtap
Jernmangel hos menn skyldes gastrointestinalt blodtap til det motsatte er bevist
Menstruasjon/graviditet var vanligste årsak hos kvinner:
- MEN; ikke overse GI-blodtap av den grunn. Nåtidens premenopausale kvinner blør mindre vaginalt pga. gestagen prevensjon/hormonspiraler etv.
Nedsatt absorbsjon (f.eks. v/cøliaki) eller ekstremt kosthold er alle sjeldne
Bariatrisk kirurgi gir hyppig jernmangel
Hva er et viktig prinsipp ved jernmangelanemi?
Bare ca. 70% av GI-cancere har pos. hemofec
Derfor:
- Gastroskopi og evt. colonoskopi hos alle menn og kvinner over fertil alder
- Hos kvinner i menstruerende alder ved pos. hemofec eller ved annen klinisk mistanke
Hvordan behandler man jernmangelanemi?
Hva er ofte problemet med denne typen behandling?
Jerntabletter:
- Jern substitueres best med maks 1x daglig po., ofte er 3 dager i uken nok
I.v jern kan gis og ofte nødvendig etter bariatrisk kirurgi
- Ved graviditet er toleransen for po. jern enda dårligere
Manglende effekt av jernbehandling skyldes ofte dårlig compliance (pga. kvalme, obstipasjon mm.)
- Ved manglende compliance; prøv lavere dose. Prøv jerntabl. til natten for å sove over bivirkninger
Hva menes med megaloblastanemi?
Sjelden anemiform med karakteristisk morfologi:
- Makroovalocytose og hypersegmentering i granulocytter i blod (> 5 segmenter)
Interferens med DNA syntese pga. B12- eller folatmangel fører til at kjernen modner langsomt og Hb-syntesen fortsetter
Fører til store og hemoglobinrike erytrocytter, dvs:
- ↑ MCV/MCH
Dette vil si:
- Lav Hb med høy MCV (> 105)
- Ofte lave hvite/trc
- Ineffektiv celleproduksjon med tegn til hemolyse
- LDH økt, ofte >10x normal
- s-B12/s-folat nedsatt
Hvordan kan man vurdere mangel på vitamin B12?
s-B12 < 100 pmol/L er tegn på (ganske) sikker mangel
Funksjonell B12 mangel kan forekomme ved høyere verdier:
- Opp mot 200 pmol/L
Forhøyet s-homocystein og s-metylmalonsyre (MMA) i gråsonen; 100-200 pM
Hvem er i faresonen for B12 mangel?
Hvilke symptomer er vanlig?
Pasienter med kronisk autoimmun gastritt (anemia perniciosa) har ofte autoantistoffer mot parietalceller (90%) og intrinsic factor (50%)
Nevrologiske symp. sjelden, men forekommer
- Typisk nevropati først i overex.
Nevrologiske symp. kan bedre betydelig ved behandling som bør gis iv. initialt
Hvordan behandler man B12 mangel?
T.Behepan tabl. 2 mg dg i 1 mnd., så 1 mg dg. livet ut
Haster det (nevrologi):
- 1 mg cyanocobalamin im. dg. x 5 deretter depotpreparat med hydroxycobalamin 1 mg hver 3. mnd.
Im; intramuskulært
Hva er årsaken til folatmangel?
Hvordan behandles dette?
Malabsorbsjon:
- Cøliaki
- Ventrikkelreseksjon
- Bariatrisk kirurgi
- Crohns
- Antiepileptika; Fenytoin
Lavt inntak i kosten:
- Aleneboende menn
- Demente
- Alkoholikere
- Småbarn
Økt forbruk:
- Graviditet
- Amming
- Vekst
- Hemolyse
- Kreftsykdom
Behandling:
- Folinsyre 0.4 mg daglig eller multivitaminpreparater